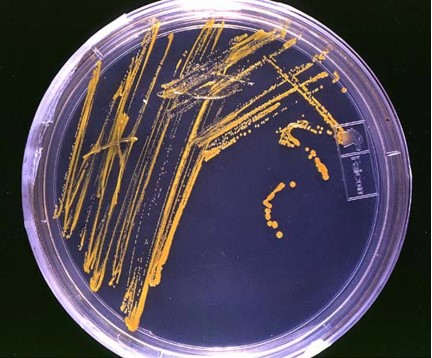

Introduction to the Plant Microbiome
Crop Insights
Written by Mark Jeschke, Ph.D., Pioneer Agronomy Manager
Crop Insights
Written by Mark Jeschke, Ph.D., Pioneer Agronomy Manager
The fact that microorganisms can play an important role in crop growth and yield should not come as a surprise to those working in crop production. Producers of leguminous crops such as alfalfa or soybeans understand that a significant portion of the nitrogen those plants need to grow comes from bacteria that colonize the roots. In return, the bacteria receive organic acids from the plants as a source of carbon and energy. The relationship between the organisms benefits both of them – a type of symbiosis referred to as mutualism.
What is likely not as well understood, is the fact that this type of interaction is not limited to legumes, it occurs in all plants and can involve numerous types of microorganisms that interact with the plant in a variety of ways. Broadly speaking, the term microbiome refers to the community of microorganisms living together within a given habitat.

Figure 1. The symbiotic relationship between legume plants and Rhizobium bacterial species was first discovered in 1888. Since then, we have learned that it is just one of many symbiotic interactions between plants and microorganisms.
All animals and plants form associations with microorganisms, including protists, bacteria, archaea, fungi, and viruses. Plants are colonized by a wide diversity of microorganisms that live both on and inside plant tissue. These microorganisms can interact with the host plant and each other and can have significant effects on plant health and productivity. This complex community of microorganisms is referred to as the plant microbiome.
Scientific study of microorganisms began in the 17th Century with the invention of the microscope, which allowed them to be observed for the first time. Research in the 19th Century showed that microorganisms were the cause of diseases in plants. Initially, it was believed that healthy plants were free of microorganisms and that their presence was exclusively associated with disease. However, research in the 19th and early 20th Century demonstrated the existence of beneficial microorganisms in plants. One of the most important of these early discoveries was nitrogen-fixing bacteria in the root nodules of legumes in 1888.

Figure 2. Robert Hooke's microscope from Scheme I. of his 1665 Micrographia. The invention of the microscope facilitated the first study of microorganisms in the 17th Century.
Subsequent research revealed that only a small proportion of microorganisms are associated with disease or pathogenicity. The overwhelming majority of microorganisms are essential for ecosystem functioning and can have beneficial interactions with macroorganisms as well as other microorganisms. The term endophyte was coined to refer to microorganisms that spend at least a portion of their lifecycle inside plants without causing any apparent harm (Hallmann et al., 1997).
Historically, understanding of plant-microbe interactions has been limited by the need to isolate and culture microbes in order to study them. Not all microbes can be cultured in a laboratory environment, so research was confined to those that can. This left numerous microbes largely uninvestigated. Furthermore, research on plant-microbe interactions commonly involved host plants grown in controlled, optimized conditions that may not reflect field conditions where environmental variables and stresses can influence microbe activity.
Figure 3. For a long time, the study of microorganisms was largely confined to those organisms that could be cultured in a laboratory environment.
Recent advances in high-throughput genome sequencing and several other technologies have greatly expanded the ability to study complex microbiomes. This has led to an increased focus on how microorganisms influence plant growth and yield in crop species and opportunities to alter or enhance the microbiome to increase crop productivity and resilience against pests and abiotic stress. Areas of research that are rapidly expanding our understanding of plant microbiomes include:
The first step in understanding plant-microorganism interactions often involves characterizing the microbiome – quantifying which species (or categories of species) are present and in what quantities. Organisms whose presence correlates to crop yield can then be evaluated further to determine how they are interacting with the plant and environmental conditions that can increase or decrease their activity.
This growing body of research on plant-microbe interactions has led to a rapid proliferation of microbial products in the crop input marketplace, all seeking to improve crop health and productivity by altering some aspect of the microbiome. Navigating this marketplace of microbial products and understanding how we might influence the microbiome to increase yield requires some basic knowledge of how the plant microbiome works – the types of organisms involved, how they colonize the plant, and what they do.
An important aspect of the plant microbiome to understand is just how vast it can be in terms of the number and diversity of organisms. A single gram of soil can contain up to a billion bacterial cells representing tens of thousands of different species (Roesch et al., 2007), and that is just one of the types of microorganisms that can form associations with plants. Several types of microorganisms can function as symbionts of plants. Bacterial and fungal symbionts are the most well-known and studied, but the plant microbiome can also include archaea, protists, oomycetes, and viruses.
Bacteria are single-celled microorganisms found nearly everywhere on Earth and are the dominant component of plant microbiomes. Bacteria are prokaryotes, meaning they lack a true nucleus and membrane-bound organelles. Their genetic material consists of a single, circular DNA molecule. Some are autotrophs, producing their own food through processes like photosynthesis, while others are heterotrophs, relying on external sources of organic carbon. Bacteria play crucial roles in nutrient cycling and decomposition. They help break down organic matter into simpler substances, making nutrients available to plants and other organisms.
Bacteria in the genus Rhizobium are the most well-known bacterial symbiont of plants. The bacteria colonize the root cells of certain plant species to form nodules where they convert atmospheric nitrogen gas into ammonia that the plants can use for their growth. In turn, the host plants provide the bacteria with carbohydrates in the form of sugars and other organic compounds through photosynthesis.

Figure 4. Bacteria are the largest and most well-studied component of plant microbiomes.
Fungi are a diverse group of eukaryotic organisms. Fungi are heterotrophs, which means they cannot produce their own food through photosynthesis. Instead, they obtain nutrients by absorbing organic matter from their surroundings. Fungi have significant ecological importance. They form symbiotic relationships with plants (mycorrhizae) and help plants absorb water and nutrients from the soil. Fungi are also important decomposers, breaking down organic matter and recycling nutrients in ecosystems. The morphology of fungi can be highly variable, allowing them to inhabit diverse environments.
Mycorrhizal fungi are one of the most well-known fungal symbionts of plants. Plants provide mycorrhizal fungi with carbohydrates produced through photosynthesis that serve as a source of energy for the fungi. Mycorrhizal fungi, with their extensive hyphal networks, extend the effective surface area of plant roots, enabling better absorption of water and nutrients, especially phosphorus and nitrogen, from the soil.
Protists are eukaryotic microorganisms, which means their cells have a true nucleus and membrane-bound organelles. Some are unicellular while others are multicellular. Protists can be found in various habitats, including freshwater, marine environments, soil, and the bodies of other organisms. Some protists, like algae, are photosynthetic and play a vital role in aquatic ecosystems by producing oxygen and serving as the base of the food chain.
Protists can influence host plants directly, as well as indirectly through their interactions with bacteria and fungi (Nguyen et al., 2023). Known beneficial functions of protists associated with crop species include effects on biomass allocation and nitrogen translocation in the root system of wheat by Acanthamoeba castellanii (Henkes et al., 2018) and suppression of Fusarium rot in faba bean by Rosculus terrestris (Bahroun et al., 2021).
Archaea are a distinct group of single-celled microorganisms that, like bacteria, are prokaryotes. However, differences in cell wall composition, membrane structure, and genetic processes highlight their distinct evolutionary paths and separate them into two distinct domains of life. Archaea was first recognized as a separate domain of life in the late 1970s, largely based on the work of microbiologist Carl Woese at the University of Illinois. Archaea share similarities with both bacteria and eukaryotes (organisms with complex cells). Archaea are known for their ability to thrive in extreme environments, such as hot springs, acidic environments, and deep-sea hydrothermal vents.
Haloarchaea are a class of archaea that can tolerate extremely high salt concentrations. Some genera of haloarchaea can solubilize phosphorus. Recent research suggests archaea colonizing the rhizosphere of plants in hypersaline soils may play a role in phosphorus nutrition, helping the plants to survive in extreme saline environments (Yadav et al., 2015).
Although often referred to as "water molds," oomycetes are not fungi but belong to a distinct lineage of fungus-like microorganisms. This classification includes some well-known plant pathogens, such as Pythium and Phytophthora species.
Although the majority of known oomycete species are plant pathogens, some can form mutualistic relationships with certain plant species. These associations involve oomycetes and plants working together in a way that mirrors the mutualistic relationships between plants and fungi.
Viruses straddle the line between living and non-living things. Viruses are not made up of cells; they consist of genetic material (either DNA or RNA) surrounded by a protein coat called a capsid. Viruses lack the cellular machinery necessary for metabolism and energy production. They cannot carry out essential life processes on their own and must rely on host cells to replicate and reproduce. Viruses are usually highly specific to the type of host organism and even specific cell types within that organism.
Viruses have long been associated with disease; however, recent advances in next-generation sequencing have begun to reveal the mutualistic relationships that exist between plants and viruses (Fadiji et al., 2022, Roossinck, 2015a). Endophytic viruses have been shown to increase tolerance of plants to abiotic stress in some instances (Roossinck, 2015b).
Microorganisms live both on the external surface of a plant and inside the plant and can colonize both above- and below-ground tissues. The term endophyte refers to a microorganism that colonizes internal plant tissues for at least a portion of its lifecycle. The endosphere consists of all microorganisms that live inside the plant (endophytes), including above- and below-ground plant tissues. Epiphytes are microorganisms that adhere to external plant surfaces such as roots, shoots, leaves, and flowers.
The rhizosphere is the volume of soil directly surrounding a plant’s roots where the microbiome is directly influenced by root exudates. The rhizosphere can contain many types of bacteria, fungi, and other microorganisms that feed off dead root cells or proteins and sugars exudated by the roots. The rhizoplane refers to the interface where the root tissue and soil particles contact and interact with each other. Bulk soil refers to soil that is not influenced by plant roots (i.e., everything that is not part of the rhizosphere.
The phyllosphere consists of the total aboveground surface of a plant – including stems, leaves, flowers, and fruits – that can serve as a habitat for microorganisms. Compared to the rhizosphere, the phyllosphere is a much more dynamic and harsher environment, subject to ultraviolet radiation, rainfall, and diurnal variations in temperature. Consequently, the phyllosphere microbiome is generally less abundant and diverse than that of the rhizosphere.
A close biological interaction between two dissimilar species is referred to as symbiosis. The term symbiosis is often used to refer to relationships that are mutually beneficial, but this is only one of the three main types of symbiotic relationships:
Mutualism refers to a relationship in which both species benefit from the interaction.
Commensalism is a relationship that benefits one species while the other is neither helped nor harmed.
Parasitism is a relationship in which one species benefits at the expense of the other. The parasite benefits by deriving nutrients from the host, which is harmed in the process.
In the context of crop management systems and, specifically, examining how the microbiome might be utilized to increase crop productivity, interest is primarily focused on mutualistic relationships – microorganisms associated with crop species that provide a benefit to the host plant.
Research thus far has demonstrated several beneficial effects that microbial symbionts can provide in crop plants:
The most well-known function of microbial symbionts of plants is nitrogen fixation. This is carried out by species of bacteria and archaea with nitrogenase enzymes – known as diazotrophs – that are able to fix gaseous nitrogen in the atmosphere into forms usable to plants. Diazotrophs can colonize and associate with plants in a variety of ways.
Rhizobium species colonize the root nodules of legumes. Azospirillum species are free-living soil bacteria that associate with the roots of various plants, including grasses and cereals (Gomez-Godinez et al. 2018). Methylobacterium symbioticum colonizes corn plants through the leaves where it scavenges methanol produced by the plant as a food source (Pascual et al., 2020; Vera et al., 2023).

Figure 5. Methylobacterium symbioticum, the active ingredient in Utrisha® N on the surface of a plant leaf. M. symbioticum enter the plant through the stomata and rapidly colonize the entire plant.
Two strains of bacteria (Pseudoduganella and Bosea species) that colonize the roots of corn plants have been shown to boost corn growth under chilling conditions (Beirinckx et al, 2020). Arbuscular mycorrhizal fungi can improve corn tolerance to drought stress by regulating aquaporins (membrane proteins that serve as channels in the transfer of water) in corn (Quiroga et al., 2017).
Several genera of bacteria have shown the ability to promote growth in corn through the production of plant growth hormones (Arshad and Frankenberger, 1991; Shi et al., 2017).
Microorganisms can increase phosphorus uptake in plants by facilitating the transport to the roots via mycorrhizal fungi (Smith and Read 2008) or by solubilization or mineralization of phosphorus-containing molecules (Mander et al. 2012).

Figure 6. Roots colonized by Bacillus amyloliquefaciens (shown by green fluorescence), the active ingredient in Utrisha® P.
The active ingredient in Utrisha® P, Bacillus amyloliquefaciens strain FZB45, colonizes plant roots (Figure 6) and increases phosphorus availability by producing phosphatase enzymes and organic acids that solubilize organic phosphorus molecules into plant-available forms and producing siderophores that degrade iron-phosphate compounds by chelating iron.
Some bacterial and fungal species are associated with enhanced disease resistance in plants. Methylobacteria have been shown to induce disease resistance via production of antimicrobial compounds and have positively correlated with disease resistance in corn (Wallace et al., 2018). Trichoderma harzianum is a fungal species that interacts with plants roots and has been shown to trigger induced systemic resistance to foliar disease in corn (Saravanakumar et al. 2016).
Recent advances in technical and computational tools have facilitated a rapid expansion in research on the microbiomes of crop species. In the production agriculture sphere, this growth in research has led to a proliferation of biostimulants, biopesticides, and other biological products that offer the potential to improve crop health and yield by influencing the composition of the crop microbiome.
Microbiomes are a vast and complex network of life, and much remains to be learned about how microorganisms can be leveraged to improve crop productivity and resilience. In corn, there are large disparities in the quantity of research that has been done on different components of the microbiome. The corn rhizosphere (belowground) has been researched to a much greater extent than the phyllosphere (aboveground). Bacterial communities have been researched far more than fungal communities, and both have been research more than other types of microorganisms (Singh and Goodwin, 2022).
Inconsistencies between microbiome studies has been a major issue. Differences in results may be driven by discrepancies in study designs and methods but may also be driven by environmental differences (Singh and Goodwin, 2022). Likewise, results of agricultural field studies with biostimulant products have also often been inconsistent. One likely reason for this the fact that any microorganism applied to a crop plant is entering an environment where it must interact and compete with billions of other microorganisms that are already there and may be better adapted to the environment (Peltier et al., 2023).
Numerous environmental and management factors can influence the composition of the crop microbiome, so the microbial community that a microbial product encounters can vary from field to field. Adding to that variability is the fact that the unique set of environmental conditions in a field in a given year can have a large impact on whether a biological product produces a measurable effect. A nitrogen-fixing bacteria, for example, may function exactly as intended but not produce a significant yield gain if plant-available nitrogen is already abundant in a field.
Despite these challenges, tremendous opportunities exist for using the crop microbiome to increase crop health and productivity. Research in this area will continue to expand and will undoubtedly help overcome obstacles and open up new opportunities. The need for sustainable solutions for existing issues in agricultural production and to drive gains in crop yield and resilience in the coming years will continue to fuel growth in this area.
In the agricultural marketplace, the terms biological and microbial are sometimes used interchangeably to refer to any non-synthetic crop input product; however, they are not the same thing.
The term biologicals in agriculture encompasses a diverse and rapidly growing array of non-synthetic crop production inputs. Generally, these are crop treatments comprised of living organisms or substances derived from living organisms. Examples of biologicals include beneficial insects, microorganisms, and plant extracts. Biologicals can benefit a crop directly through their interactions with the crop plant or indirectly through their effect on other organisms that can impact the crop such as insects or nematodes.
Microbials are a subcategory of biologicals comprised of living microorganisms such as fungi, bacteria, protozoa, and viruses. As with the broader category of biologicals, microbials may interact with the crop plant directly or via their effect on another species. Microbials that affect the plant directly by colonizing on or within plant tissues function as a part of the plant’s microbiome.
The foregoing is provided for informational use only. Please contact your Pioneer sales professional for information and suggestions specific to your operation. Product performance is variable and depends on many factors such as moisture and heat stress, soil type, management practices and environmental stress as well as disease and pest pressures. Individual results may vary.
Pioneer® brand products are provided subject to the terms and conditions of purchase which are part of the labeling and purchase documents.